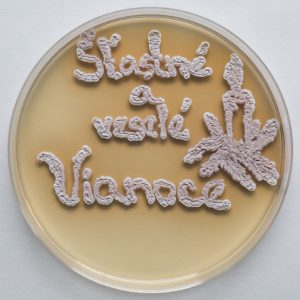
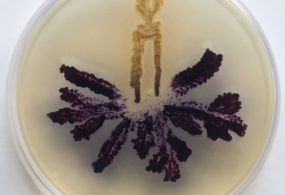

Hoci sa molekulárni biológovia zaoberajú celkom serióznou vedou, občas v rámci svojho odboru ponúknu aj netradičné výsledky. Tak vznikli aj vianočné a zimné obrázky.
Každý deň po nej chodíme a ani si neuvedomujeme, čo všetko skrýva. Pôda nie je iba zdroj živín pre vegetáciu, ale aj veľký mikrosvet, v ktorom prebiehajú početné deje. Mikroorganizmy v nej žijúce ju spájajú s okolitým svetom a umožňujú život na zemskom povrchu rastlinám, živočíchom a človeku. Ich činnosťou a vplyvom neustále sa meniacich vonkajších podmienok dochádza v pôde k dôležitým premenám. Najmä koncom jari a začiatkom jesene, keď má pôda dostatočnú teplotu a vlhkosť, vytvárajú pôdne mikroorganizmy množstvo užitočných biologicky aktívnych látok. Mnohé z týchto látok využívajú na svoju ochranu, aj na komunikáciu s inými organizmami, rastlinami či živočíchmi, ktoré sa nachádzajú v ich blízkosti.
Pôdne baktérie streptomycéty z kmeňa aktinomycét sú v pôde zastúpené vo veľkej miere. Rozkladajú organickú hmotu na základné prvky, čím zabezpečujú kolobeh prvkov v prírode. Okrem toho uvoľňujú do prostredia látku geosmín, ktorú poznáme ako typickú vôňu zeme po letnej búrke alebo daždi. Streptomycéty sú najväčšími producentmi antimikrobiálnych látok, napríklad antibiotík (viac ako 70 %), ktoré denne využívame v humánnej a veterinárnej medicíne. Už v roku 1940 S. A. Waksman a jeho spolupracovníci izolovali z pôdy veľké množstvo rôznych druhov streptomycét, ktoré laboratórne testovali. Ich práca viedla k objavu streptomycínu, prvého antibiotika využívaného v medicíne na liečbu tuberkulózy.
Farebné baktérie
Vedcov, čo skúmajú neviditeľný a užitočný mikrosvet, potešia baktérie pri práci neraz aj svojím vzhľadom a širokou škálou farebných pigmentov. V prírode existuje veľa farebných látok, ktoré majú pre dané organizmy rôznu, okrem iného aj ochrannú funkciu. Ľudia ich využívajú v potravinárstve, medicíne, textilnom priemysle či umení. Snáď najznámejšim zástupcom je indolové farbivo indigo, známe už starovekým Rimanom a Egypťanom. Pôvodne sa získavalo z rastlín, napríklad z listov rastliny Isatis tinctoria (Európa) alebo Indigofera tinctoria (Afrika, Ázia, India a Južná Amerika). Podobné modré pigmenty však produkujú aj mnohé baktérie, napríklad indigoidín druh Arthrobacter atrocyaneus a A. polychromogenes, Streptomyces aureofaciens a S. lavendulae a aktinorhodín druh Streptomyces coelicolor. Tvorba pigmentov je v každom mikroorganizme iná a ovplyvňujú ju rozličné podmienky (výživové podmienky, pH, prevzdušňovanie, teplota). Možno práve rôzne druhy streptomycét sú nevyužitým zdrojom užitočných biopigmentov.
Maľovanie v Petriho miske
Maľovanie týmito živými pôdnymi baktériami alebo výťažkami z ich pigmentov z bakteriálnych kultúr môžu vizuálne vytvoriť, vďaka ich myceliárnemu rastu, kompaktný obrázok v Petriho miske. Ako na to? Laboratórnym inokulačným očkom alebo špáradlom nakreslíme po povrchu živného média obrázok. Petriho misku potom vložíme do inkubátora s 30 °C a po 2 až 3 dňoch už môžeme vidieť prvé obrysy. Pigmentácia sa zvýrazní po 5 až 7 dňoch. Hotový obrázok azda svojím vzhľadom poteší malých aj veľkých.
Schopnosti mikroogranizmov v pôde sú veľké, nie však nevyčerpateľné. Dôsledkom znečistenia pôdy sa menia jej základné vlastnosti a hynú mnohé druhy mikroorganizmov. Práve preto je dôležitá harmónia medzi prírodou a spoločnosťou.
Mgr. Renáta Nováková, CSc.
Ústav molekulárnej biológie SAV
Bratislava
Obrázky kreslila autorka, použila druhy pôdnych baktérií: Streptomyces aureofaciens a Streptomyces coelicolor
Foto Mgr. Jana Makroczyová